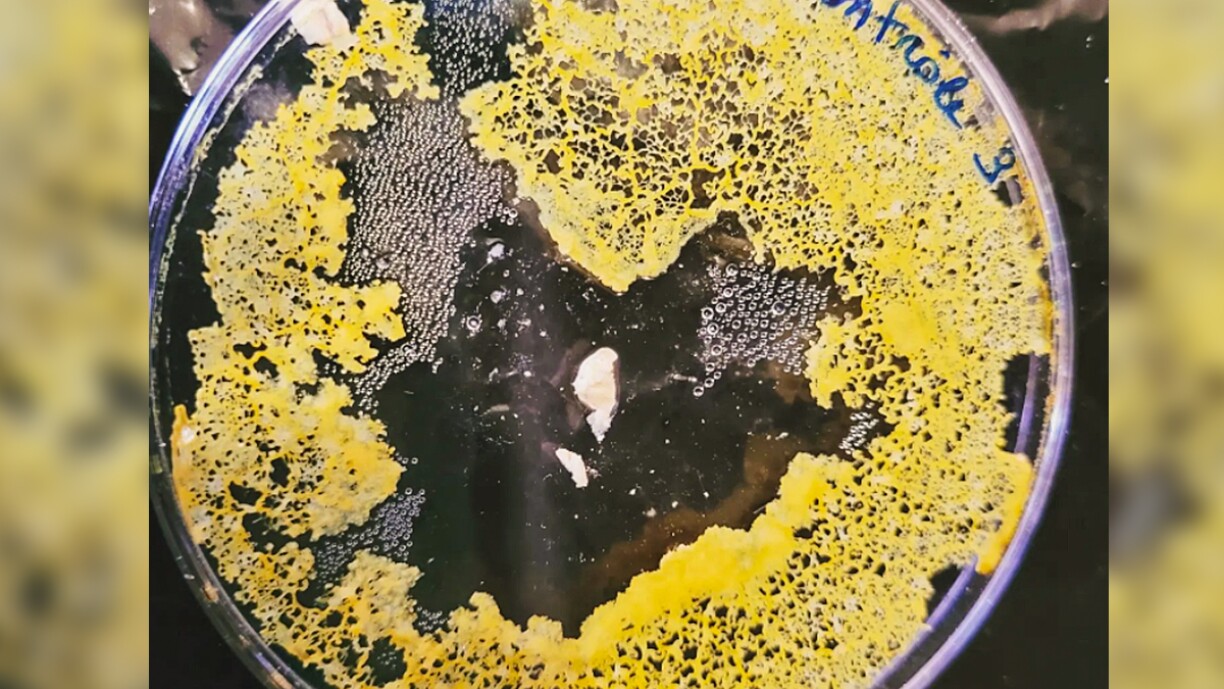
BLOB: 200 familles belges volontaires pour accueillir une mystérieuse créature unicellulaire

Le parc à thème scientifique Sparkoh près de Mons, a proposé à 200 familles belges d’en adopter un dans le cadre d’une expérience réunissant quelque 15.000 familles à travers l’Europe.
De son nom latin le physarum polycephalum , le blob n’est ni une plante, ni un champignon, ni un animal. Alors qu’est-ce ? Il s’agit d’une forme de vie composée d’une seule et même cellule. Intelligent, bien que dépourvu de cerveau, le blob est capable d’explorer son environnement et de s’adapter en fonction.
Pour ce faire, il utilise ses longs doigts jaunes et gluants afin de s’étendre. Aussi, il peut doubler de volume en l’espace d’une journée. Avec le temps, le blob peut même atteindre une superficie de 10 mètre carrés. Plus étonnant encore, le blob serait immortel.
Dans la nature, les blobs vivent dans les bois à l’abri de la lumière, et se nourrissent de bactéries et de champignons qu’ils trouvent sur leur chemin.
Ainsi, 200 familles belges accueilleront chez elles cette petite créature. Leur mission sera de réaliser des expériences scientifiques ayant pour but d’aider la recherche scientifique. Un kit de recherche a été distribué aux familles participantes contenant un blob séché, qu’il faudra ranimer en le plongeant dans l’eau.